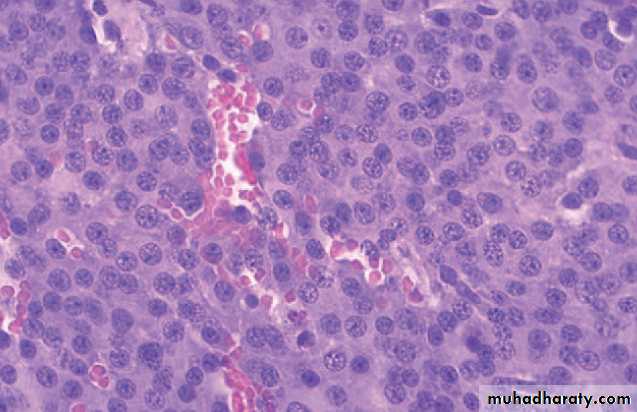

Dr.Zahraa Osama Yehya
Pathology departmentNinevah college of medicine
PATHOLOGY OF THE ENDOCRINE SYSTEM
The endocrine system contains a highly integrated & widely distributed group of organs that orchestrates a state of metabolic equilibrium, or homeostasis between the various tissues of the body.
The endocrine system comprises two main components :
• The classical endocrine organs e.g. pituitary, thyroid, adrenal, parathyroid, islets of Langerhans in pancreas.• The diffuse endocrine system consist of cells dispersed singly or in small group throughout various non-endocrine organ including G.I.T., lung, Skin.
Endocrine diseases can be generally classified as:
• Diseases of underproduction (hypo-) or overproduction (hyper-) of hormones and their biochemical & clinical consequences.• Diseases associated with the development of mass lesions (nonfunctional or associated with underproduction or overproduction of hormones).
THE PITUITARY GLAND
This is a small, bean-shaped structure that lies at the base of the brain within the confines of the sella turcica. It is connected to the hypothalamus by a "stalk," composed of axons extending from the hypothalamus.
The pituitary is composed of two morphologically and functionally distinct components: the anterior lobe (adenohypophysis) and the posterior lobe (neurohypophysis).
The adenohypophysis, in H&E stained sections, shows a colorful collection of cells (cellular pleomorphism) with basophilic, eosinophilic or poorly staining ("chromophobic") cytoplasm.
Immnohistochemistry (and sometimes electron microscopy) is usually employed in typing the hormone (s) present in various pituitary lesions.
The release of trophic hormones is under the control of releasing or inhibiting factors produced in the hypothalamus.
Diseases of the pituitary , accordingly , can be divided into those that primarily affect the anterior lobe and those that primarily affect the posterior lobe.
Symptoms of pituitary diseases can be divided into the following:
• Hyperpituitarism.• Hypopituitarism (loss or absence of 75% or more pituitary parenchyma, congenital or acquired).
• Local mass effects (visual field abnormalities, increased intracranial pressure, cranial nerve palsy, obstructive hydrocephalus, seizure …)
Causes:
A. Pituitary; usually anterior lobe• Adenoma (the most common cause)
• Hyperplasia
• Carcinoma (rare).
B. Extra-pituitary causes
• Hormone producing extra-pituitary tumors (ectopic hormone production)• 2. Certain hypothalamic disorder
Hyperpituitarism
• Classified according to the hormone(s) produced by the neoplastic cells; (detected by IHC).
• Can be functional (associated with hormone excess with their associated clinical manifestations) or silent.
Pituitary adenomas
• usually composed of a single cell type and produce a single predominant hormone. However, some adenomas can secrete two hormones (e.g. growth hormone and prolactin). Other adenomas are hormone negative.
• Adenomas are divided on the basis of whether the size is less or exceeds 1 cm. (microadenomas and macroademomas respectively).
• Prolactinomas (Prolacin cell adenomas).
• Growth Hormone-Producing (somatotroph cell) adenomas.• Corticotroph (ACTH) cell adenomas.
• Gonadotroph adenomas (luteinizing hormone [LH]-producing and follicle-stimulating hormone [FSH]producing)
• Thyrotroph (thyroid-stimulating hormone [TSH]-producing) adenomas
Classification of pituitary adenomas
• Mixed (plurihormonal) adenomas.
• Nonfunctioning pituitary adenomas (hormone-negative (null cell) adenomas) 25% of all pituitary tumors; they typically present through their mass effects.Hormones are synthesized in hypothalamus and transported via axons to the posterior pituitary. 2 common syndromes:
• Diabetes insipidus.
• Inappropriate secretion of (high levels of) ADH. most commonly caused by ectopic production of ADH by various tumor especially small cell carcinoma of the lung.
Posterior Pituitary Syndromes
THE THYROID GLAND
• Anterior neck.
• Two bulky lateral lobes connected by a thin isthmus.• Divided into lobules, each composed of about 20-40 follicles, each lined by cuboidal to low columnar epithelium, each filled by thyroglobulin, the precursor protein of active thyroid hormone:
• T4 (Thyroxine)
• T3 (Triiodothyronine) : more potent
Normal Thyroid gland
The third hormone produced by the thyroid is calcitonin :
• produced by the parafollicular cells.• a polypeptides which lower the conc. of calcium in the blood by causing deposition of calcium in the bone.
• The follicular cells of the thyroid gland remove iodide from the plasma at a rate which is controlled by the plasma / gland iodide gradient & by TSH .
• The iodide is oxidized to iodine.
• The iodine is taken up by a tyrosine component of an intrathyroid globulin to produce mono-& di-iodotyrosine- this forms the colloid .
• Two of these molecules condense to form thyroxine tri-iodothyronine, which are coupled to globulin as thyroglobulin.
• Thyroglobulin is hydrolysed & thyroid hormones are released into the circulation.
Hormone synthesis in the thyroid gland
• A hypermetabolic state caused by elevated circulating levels of free T3 and T4.• Primary (Hyperthyroidism) or rarely, secondary (due to pituitary or hypothalamic diseases).
• The diagnosis is based on clinical features and laboratory data.
Thyrotoxicosis
• The measurement of serum TSH concentration provides the most useful single screening test for hyperthyroidism, because TSH levels are decreased in primary cases, even when the disease is still be subclinical. In secondary cases TSH levels are either normal or raised.
• Associated with hyperthyrodism:
Primary:• Diffuse toxic hyperplasia (Graves disease).
• Hyperfunctioning (toxic) multinodular goitre.
• Hyperfunctioning (toxic) adenoma.
Secondary:
TSH-secreting pituitary adenoma (rare).Causes of thyrotoxicosis
• Not associated with hyperthyrodism:
• Subacute granulomatous thyroiditis (painful).• Subacute lymphocytic thyroiditis (painless).
• Struma ovarii (ovarian teratoma with thyroid).
• Factitious thyrotoxicosis (exogenous thyroxine intake).
It is an enlargement of part or whole of the thyroid . It may be diffuse or nodular & it may be associated with a deficient , normal , or excessive production of thyroid hormone.
GOITRE
• Autoimmune activation of thyroid epithelial cells by antibodies to TSH receptors that mimic THS action.
• The most common cause of endogenous hyperthyroidism characterized by a triad of manifestations:
• Thyrotoxicosis (diffusely enlarged) (all cases).
• Infiltrative ophthalmopathy (40% of cases).
• Localized Infiltrative dermopathy (minority)
Graves disease
Graves’ causes diffuse enlargement of thyroid gland, microscopically :
• Diffuse hypertrophy & hyperplasia of thyroid epithelial cells results in the formation of small papillae projecting into the follicular lumen lacking fibrovascular core.• Pale colloid with scalloped margins.
• Mononuclear (lymphoplasmacytic) infiltates with well-developed germinal centres.
• Gross enlargement of thyroid gland (mass effect).
• It reflects impaired synthesis of thyroid hormones, mostly due to dietary iodine deficiency leading to compensatory rise in serum TSH , which in turn causes hypertrophy & hyperplasia of thyroid epithelial cells.• more commonly in females & is particularly likely to develop at a time when the thyroid gland is subjected to extra functional stress as in adolescence or pregnancy .
Diffuse & Multinodular Goitre
Any structural or functional derangement that interferes with the production of adequate levels of thyroid hormone.
Clinically: cretinism & myxedema
HypothyroidismPrimary:
• Postablative surgery, radioiodine therapy or external radiation.• Hashimoto thyroiditis.
• Iodine defeciency.
• Congenital biosynthetic defects.
• Drugs (lithium, iodides).
• Thyroid dysgenesis.
Secondary:
Pituitary or hypothalamic failure.Causes of hypothyroidism
THYROIDITIS
Acute thyroiditis :It is rare, caused by bacterial infections e.g. staph or strepto which reach the thyroid gland by one of the following ways : haematogenous, lymphatic or direct from near by focus.
Pathology : The gland is swollen & congested with interstitial inflammation .
Results : Resolution or Suppuration with abscess formation.
Specific granulomatous inflammation due to TB, sarcoidosis ,syphilis (gumma ) may occur
• Hashimoto thyroiditis (chronic lymphocytic thyroiditis).
• Subacute granulomatous (De Quervain) thyroiditis.• Subacute lymphocytic (postpartum) thyroiditis.
• Others. (rare)
Non-bacterial THYROIDITIS
• Most common cause of hypothyroidism (when iodine levels are sufficient).
• An autoimmune progressive destruction of thyroid parenchyma produced by the release of thyroid follicle constituents into the interstitial tissue & formation of auto-antibody against them.Hashimoto thyroiditis
Histologically, Hashimoto’s is Characterized by:
• loss of thyroid parenchyma.• Hurthle follicular epithelial cell changes (bright eosinophilic cytoplasm).
• mononuclear (lymphoplasmacytic) infiltates & well-developed germinal centre.
• with or without extensive fibrosis.
Neoplasms of the thyroid
??? Thyroid nodule(s) ???• Benign lesions:
• follicular adenoma
• localized non-neoplastic conditions (e.g., nodular hyperplasia, simple cyst, foci of thyroiditis, ….)
• Carcinoma of the thyroid: less than 1% of solitary thyroid nodules.
Neoplasms of the thyroid
Criteria favoring thyroid neoplasms:• Solitary nodule.
• Young patient.
• Male gender.
• History of radioactive treatment (malignant??).
• Cold nodule on thyroid scan (malignant??).
Thyroid neoplasms:
Benign: Thyroid adenoma
Malignant: Thyroid carcinomas
• Papillary carcinoma
• Follicular carcinoma
• Medullary carcinoma
• Anaplastic carcinoma
• benign neoplasm derived from follicular epithelium.
• the commonest thyroid neoplasm• most frequently in women over 30 year
• commonly as solitary nodules.
Thyroid adenomas
Thyroid adenomas:
Grossly: solitary, spherical lesion that compresses the adjacent non-neoplastic thyroid parenchyma, well-demarcated by a well-defined intact capsule.DDx.: multinodular goitre (multiple nodules, no compression, lack a well-defined capsule)
• Mic: tumor cells are arranged in uniform follicles that contain colloid, quite distinct from the adjacent non- neoplastic thyroid.
• Papillary changes: not a typical feature.
DDx. Papillary carcinoma(capsular &/or vascular invasion).
• Hurthle cell adenoma: shows Oxypil or Hurthle cell changes (occasional).
Similar to other endocrine tumors, benign follicular adenomas may show focal nuclear pleomorphism, atypia, & prominent nucleoli, all of these are known as (endocrine atypia) & by itself, this NOT considered a feature of malignancy (capsular &/or vascular invasion).• Papillary carcinoma (75-85% of cases)
• Follicular carcinoma (10-20% of cases)• Medullary carcinoma (5% of cases)
• Anaplastic carcinoma (<5% of cases)
Most thyroid carcinomas are derived from the follicular epithelium, except for medullary carcinomas, that are derived from the parafollicular, or C, cells.
Thyroid carcinomas
Papillary carcinoma:
• Most common type.
• Any age. (mean age : 40 years).
• Hx. of ionizing radiiation exposure.
Grossly:
• Solitary or multifocal
• Either well-circumscribed & even encapsulated, or infiltrative with ill-defined borders.
• Cut section: granular + papillary foci.
Mic.:
branching papillae which have fibrovascular stalk covered by single or multiple layer of cuboidal epithelium cells which range from well differentiated cells to anaplastic variety. some are composed predominantly or exclusively of follicles (follicular variants).• Dx. Is based on nuclear features:
• ground glass or Orphan Annie eye (clear nuc.).
• Nuclear grooves.
• eosinophilic intranuclear pseudo-inclusions.
• Psammoma bodies (often): concentrically calcified structures .
Follicular carcinoma:
• Age older than that of pap. Ca.• Assoc. with dietary iodine deficiency & nodular goitre.
• Hematogenous spread is common.
• Mic.: fairly uniform cells forming small follicles. With ot without Hurthle cell changes.
• DDx.: follicular adenoma (capsular &/or vascular invasion).
Medullary carcinoma
• Neuroendocrine neoplasm (Parafollicular cells).• 80% sporadic, 20% familial (MEN 2A or 2B).
• Peak incidence in the fifth to sixth decades.
• Hematogenous & lymphatic metastasis.
• Solitary nodule or multicentrality (familial).
• Mic.: composed of
• polygonal to spindle-shaped cells, may form nests, trabeculae or follicles.
• Amyloid deposits (altered Calcium mol.).
• Calcitonin expression (IHC).
Anaplastic carcinoma:
• One of the most aggressive human tumors.• Mean age of 65 years.
• Hx. Of multinodular goitre (50% of cases).
• Bulky mass + rapid growth
• Highly anaplastic cells, several histologic pattern:
• Large pleomorphic giant cells.
• Spindle cells + sarcomatous appearance.
• Mixed spindle & giant cells.
• Small cells.
ADRENAL GLAND
The adrenal gland are paired organ composed of
• Cortex• Medulla
Adrenal cortex: 3 layers:
• Zona glomerulosa (narrow, beneath the capsule)• Zona fasciculata (75% of the cortex)
• Zona reticularis (narrow, abuts the medulla)
The adrenal cortex synthesizes 3 types of steroids:
• Mineralocorticoids (aldosterone, zona glomer.)• Glucocorticoids (cortisol, mostly in zona fasc. + small contribution from zona retic.)
• Sex hormones (estrogens & androgens, zona retic.)
Adrenal medulla is composed of chromaffin cells, which synthesize & secrete catecholamines (mainly epinephrine)
Three distinctive syndromes:
• Hypercortisolism (Cushing syndrome).• Hyperaldosteronism.
• Adrenogenital or virilizing syndromes.
Adrenocortical hyperfunctionHyperadrenalism
Eitiology:
• Administration of exogenous corticosteroids (most cases)• Primary hypothalamic pituitary diseases, associated hypersec. of ACTH (~ half the cases)
• Primary adrenal neoplasms :hyperplasia, adenoma or carcinoma (10-20% of cases)
• Secretion of ectopic ACTH from non-endocrine tumor e.g. small cell carcinoma of the lung (remaining cases)
HypercortisolismCushing syndrome
Excessive aldosterone production causing Sodium retention & Potassium excretion, with resultant hypertension & hypokalemia, 2 types:
• Primary (hyperplasia, adenoma or Conn syndrome): with suppression of renin-angiotensin system.
• Secondary to activation of renin angiotensin sys. (decreased renal perfusion, hypovolemia, pregnancy-estrogen-induced).
Hyperaldosteronism
Excessive androgens adrenocortical secretion, 2 settings:
• Adrenocortical neoplasms (usually virilizing carcinomas)• Congenital adrenal hyperplasia (CAH): a group of AR disorders char. By steroids biosynthesis defects, usually cortisol, the commonest subtype is due to enz. 21 hydroxylase def. , decreased cortisol sec. causes compensatory increased ACTH sec. stimulating androgens production.
Adrenogenital (virilizing) syndrome
• Primary acute adrenocortical insufficiency (adrenal crises), causes by any stress that taxes the limited physiological adrenal reserves.
• Primary chronic adrenocortical insufficiency (Addison disease, an autoimmune progressive destruction of the adrenal cortex, or infectious (TB), AIDS, metastatic carcinomas, …)
• Secondary adrenocortical insufficiency .
Adrenocortical insufficiency
The most important disease of the adrenal medulla are neoplasms including:
• Neuronal neoplasms (neuroblastomas & more mature ganglion cell tumors).• Pheochromocytomas (chromaffin cell tumors).
Adrenal medulla
Chromaffin cell tumors, which, like their non-neoplastic counterparts, synthesize & secret catecholamines & other peptide hormones.
Rule of 10s:
• 10% : bilateral.• 10% : malignant.
• 10% : extra-adrenal (Paragangliomas).
• 10% : in association with one of familial syndromes (MEN, neurofibromas …).
Pheochromocytoma
Group of inherited diseases resulting in proliferative lesions (hyperplasia, adenomas & carcinomas) of multiple endocrine organs.
Multiple endocrine neoplasia ( MEN ) syndromes
MEN syndromes have certain distinctive features that contrast with their sporadic counterparts:
• Younger age.
• Arises in multiple endocrine organs, either synchronously or metasynchronously.
• Multifocality (even in one organs).
• More aggressive, high recurrence rate.
Types:
• MEN 1: the 3Ps syndrome.
• MEN 2 (2A & 2B)
THANK YOU